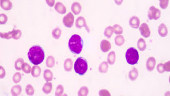
Blinatumomab Improves Survival in Acute Lymphoblastic Leukemia

Blinatumomab
Blinatumomab Improves Survival in Acute Lymphoblastic Leukemia
Dhaka, Sep 26, UNB -Two phase 3 studies evaluating blinatumomab (Blincyto, Amgen) in B-cell acute lymphoblastic leukemia (ALL) showed positive results for treatment benefit, Amgen reported. According to the press release, the 20120215 study met its primary endpoint of event-free survival for blinatumomab compared with conventional chemotherapy in pediatric patients with high-risk, B-cell ALL at first relapse. Additionally, the Children’s Oncology Group AALL1331 trial showed a strong trend toward improved disease-free survival and improved overall survival, markedly lower toxicity, and better minimal residual disease clearance for blinatumomab compared with chemotherapy, Pharmacy Times reports.
6 years ago